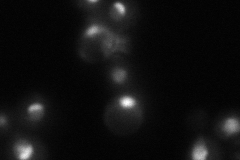
YLR003C
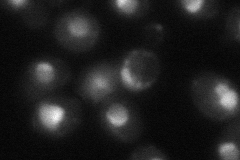
YLR003C
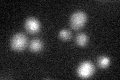
YLR003C
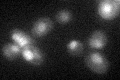
YLR003C

View description
Subunit of U3-containing 90S preribosome processome complex involved in production of 18S rRNA and assembly of small ribosomal subunit; overexpression rescues supressor mutant of mcm10; null mutant is viable
Localization:
Intensity:
Fold change:
Significance:
-
C’ GFP library in SD

nucleus32.52 -
N' NOP1pr-GFP in SD

nucleolus117.934 -
N' TEF2pr-mCherry in SD

nucleus,nucleolus177.967 -
N' NATIVEpr-GFP in SD
nucleus,nucleolus27.6667 -
N' TEF2pr-VC and Cyto-VN in SD
nucleus,nucleolus50.4472 -
C’ GFP library in SD+DTT
nucleus21.820.67Yes -
C’ GFP library in SD+H2O2
nucleus26.760.82No -
C’ GFP library in Starvation Media

nucleus20.130.61Yes -
C’ GFP library on the background of Pup2-DaMP

nucleus -
C’ GFP library on the background of CCT mutant

nucleus29.10390.894682No
